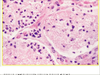
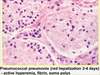

11.18.2013 - Pulmonary Infections 2, Pathology Flashcards
(83 cards)
1
Q

A

1
Q

A

1
Q

A

1
Q

A

2
Q

A

3
Q

A

3
Q

A

3
Q

A

3
Q

A
Thrombus aspergillosis
4
Q

A

5
Q

A

5
Q

A

5
Q

A

6
Q

A
Histoplasmosis
8
Q

A

8
Q

A

9
Q

A

9
Q

A

10
Q

A

11
Q

A

13
Q

A

14
Q

A

16
Q

A

17
Q

A

17


18


19


20


22


22


23


24


26

Candida bronchopneumonia
26


27


27


28


29

Aspergillus
30


31


32


33


35


37


39


40

Histoplasmosis
41


43

43


44


45


46


47

Candida

48


49


50


51

Myc avium
52


53


55


57

Histoplasmosis granuloma
57


58


58


60


62


63


64


66


68


69


70


71


72


73


74


76

Lobar pneumonia on the left vs bronchopneumonia on right
77


78


79


80


82

Histoplasmosis
83

